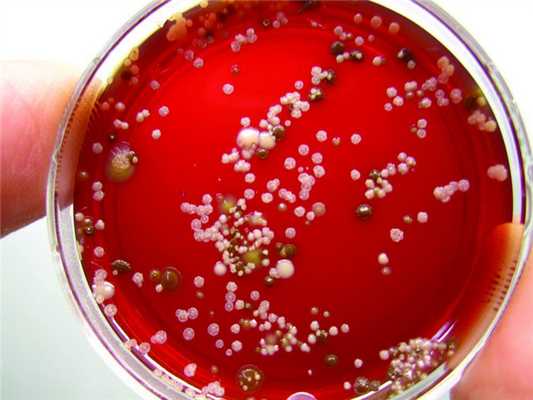
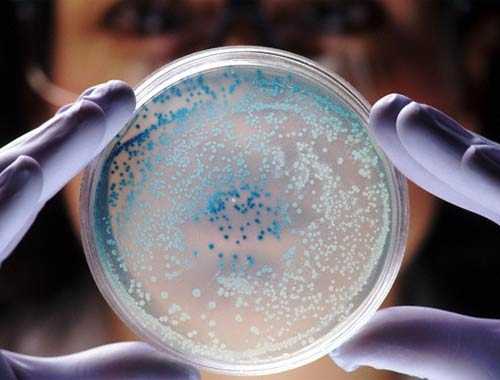

Сочетание ПЦР и культивирования. Ценность методов культивирования в стоматологии
Добавил пользователь Morpheus Обновлено: 01.12.2025
Вирусы не способны культивироваться на питательных средах, т.к. являются внутриклеточными паразитами.
1. Метод культивирования в организме чувствительных экспериментальных лабораторных животных.
Ограничения:
1) не все вирусы человека размножаются в организме лабораторных животных;
2) в организме экспериментальных животных есть иммунная система, которая может оказывать влияние на размножение вирусов.
2. Культивирование вирусов в развивающихся куриных эмбрионах.
Куриные эмбрионы имеют двухслойную экто- и энтодермальную хорион-аллантоисную оболочку; желточный мешок построен из мезодермальных клеток. Т.о., куриный эмбрион содержит ткани любого происхождения.
Куриный эмбрион не обладает иммунологической активностью.
Дешевле по сравнению с лабораторными животными. После заражения куриных эмбрионов они погибают вследствие размножения вирусов. На оболочках эмбриона могут образовыватся бляшки - мелкие зернистые образования. Вирус накапливается в жидкости куриного эмбриона.
Но: в куриных эмбрионах размножаются не все вирусы человека.
3. Метод культивирования вирусов в культуре ткани:
- для культивирования вирусов вне организма; используют эмбриональные, опухолевые клетки, которые активно размножаются в питательных средах для культуры тканей.
Типы культур тканей:
1) перевиваемые тканевые культуры - культуры обычно опухолевых клеток. Они стандартные. Их нужно постоянно поддерживать, они одинаковы во всех лабораториях мира;
2) первично-трипсинизированные тканевые культуры - культуры эмбриональных тканей, которые готовятся каждый раз по мере надобности: эмбриональную ткань измельчают, затем подвергают обработке трипсином (чтобы разрушить межклеточные связи), центрифугируют отдельные клетки. Эти культуры ткани обладают хорошими ростовыми качествами, но они не стандартны.
Для поддерживания культур ткани служат специальные синтетические питательные среды.
Культивирование вирусов под агаровым покрытием (однослойные культуры тканей) дает возможность получить потомство отдельных вирионов.
Методы регистрации размножения вирусов
1. Организм животного:
- Изменения в организме животного (болезнь).
2. Куриный эмбрион:
- Бляшки на оболочках;
3. Культура ткани:
При размножении вирусов проявляются изменения, которые не свойственны здоровым клеткам:
- ЦПЭ (цитопатический эффект);
- У культивируемых вирусов есть феномен гемадсорбции (в результате избыточного синтеза гемагглютинин экспрессируется на наружную поверхность клеток культуры ткани и они приобретают способность адсорбировать эритроциты);
- появление в клетках включений - морфологических структур, которые обнаруживаются только в зараженных вирусом клетках культуры ткани.
Виды включений:
1) по локализации:
2) По характеру окраски по Романовскому-Гимза:
Типы включений характерны для определенного вируса.
- Учет размножения вирусов в культуре ткани (метод цветной пробы - ориентировочный тест, который говорит о нарушении клеточного метаболизма):
- если культура ткани не заражена, в клетках протекают процессы метаболизма, продукты метаболизма обнаруживаются в питательной среде, рН изменяется в кислую сторону, изменяется цвет индикатора;
- если культура ткани заражена вирусом, нарушения клеточного метаболизма, продукты метаболизма не обнаруживаются в питательной среде, рН не меняется, индикатор не меняет цвет.
Культуры тканей по чувствительности к вирусам делятся на 3 группы:
1) пермессивные (поддерживает вирусную инфекцию);
2) непермессивные (не способны поддерживать вирусную инфекцию);
3) полупермессивные (вирус поддерживается, но не размножается; такие клетки передают вирусную инфекцию при контакте с другими клетками).
Особенности противовирусного иммунитета
На вирус развивается полноценный иммунный ответ.
Вирус существует в организме в двух формах. В отношении внеклеточного вируса действуют те же механизмы противомикробной резистентности, что и в отношении бактерий.
Неспецифические механизмы:
- клеточная ареактивность - отсутствие специфических рецепторов для вирусов на клетках организма;
- выделительные механизмы: чихание, кашель;
- барьерная функция кожи и слизистых оболочек;
Его особенности: при бактериальных инфекциях - лейкоцитоз, при вирусных - лейкопения. Т.к. нейтрофильные лейкоциты фагоцитируют вирус, он в них размножается и они гибнут. Защитное значение имеет фагоцитоз клеток, пораженных вирусом - на поверхности таких клеток экспрессируются вирусные белки, что делает их объектом макрофагального фагоцитоза, отсюда - моноцитоз, характерный для вирусных инфекций.
- гуморальный иммунитет: система комплемента, пропердина и вирусные ингибиторы - это химические группировки и радикалы, тождественные вирусным рецепторам, и они их блокируют.
Специфические механизмы иммунитета
Роль антител особая. Уровень сывороточных антител и устойчивость к вирусам не идут параллельно. При вирусной инфекции важно не количество антител, а их локализация в организме - на месте входных ворот или на территории пораженных тканей.
Большую роль при вирусной инфекции играет клеточный иммунитет. Это связано с тем, что инфицированные вирусом клетки становятся мишенью для цитолитического действия Т-киллеров.
При заражении двумя разными вирусами одной ткани один подавляет другой. Это явление лежит в основе невосприимчивости к вирусным инфекциям. Это
Интерферон - индуцибельный белок клеток позвоночных, появляется под влиянием интерфероногенов. Один из них - вирусная инфекция. Основная функция интерферона: подавление размножения вирусов.
Виды (в зависимости от продуцирующей клетки):
Интерферон - важнейший фактор, обладающий многогранной биологической активностью: стимулирует фагоцитоз, киллерную функцию Т-лимфоцитов, подавляет синтез комплемента, снижает гемопоэз, снижает развитие реакций гиперчувствительности замедленного и немедленного типов.
Интерферон обладает активностью в отношении внутриклеточных вирусов. Он нарушает трансляцию иРНК на рибосомах, что ведет к прекращению синтеза вирусных белков.
Интерферон появляется в клетке уже через 2 часа после заражения вирусом. Защищает практически от всех видов вирусных агентов.
Особенности интерферона:
- подавляет репродукцию любых видов вирусов (т.е. не обладает специфичностью);
- Обладает видовой специфичностью (защищает только свой вид).
Универсальность интерферона делает его незаменимым в терапии вирусных инфекций.
Интерферон обеспечивает защиту на уровне нуклеиновой кислоты, т.е. поддерживает нуклеиновый гомеостаз, а антитела и Т-лимфоциты - белковый гомеостаз.
Индукторы синтеза эндогенного интерферона:
- естественные (бактерии, вирусы, ЛПС);
- синтетические (крупномолекулярные соединения: полифосфаты, поликарбонаты и т.п.)
Применение интерферона:
- средство антивирусной терапии.
Химиотерапия вирусных инфекций
С помощью химиотерапевтических препаратов воздействуют на различные этапы взаимодействия вируса с клеткой: тормозят адсорбцию вирусов на клетках.
Основные препараты:
- производные ремантадина строго специфичны (ремантадин - при вирусах гриппа А);
- производные марборана (онковирусы, вирус оспы и т.д.);
- структурные аналоги пуриновых и пиримидиновых оснований (фтортимедин, фтордезоксиурацил, азидотимедин и т.п.);
Встраиваются в вирусную нуклеиновую кислоту → вирусы теряют инфекционность.
Специфическая профилактика вирусных инфекций
Вирусные вакцины: живые и убитые.
В настоящее время живые вакцины используется…, т.к. возможна реверсия аттенуированных штаммов.
Средство экстренной профилактики: иммунные сыворотки, интерферон.
Экстренная профилактика кори - коревой γ-глобулин. Чаще используются химические и генно-инженерные вакцины.
Принципы классификации вирусов
По типу нуклеиновой кислоты вирусы делятся на:
По размерам вириона на:
- крупные (более 100 нм);
- средние (50-100 нм);
- мелкие (меньше 50 нм).
По типу симметрии нуклеокапсида на:
По наличию или отсутствию суперкапсидной оболочки.
По антигенной структуре.
По типу репликации нуклеиновой кислоты.
Главную роль в патологии человека играют РНКовые вирусы к ним относятся:
- сем. Пикорновирусы и т.д.
ДНКовые вирусы, патогенные для человека. Это:
- вирус папилломы, полиомы и бородавок;
- Аденовирусы (постоянные обитатели глоточного кольца), могут вызывать ОРВИ, ОРЗ;
- сем. Поксвирусов, включающее вирус натуральной оспы.
Происхождение вирусов
Происхождение вирусов - вопрос, который на протяжении многих лет составлял предмет дискуссий.
Было выдвинуто три гипотезы:
1. Вирусы - потомки бактерий и других одноклеточных организмов, претерпевших дегенеративную (регрессивную) эволюцию.
2. Вирусы - потомки древних доклеточных форм жизни, перешедших к паразитическому способу существования.
3. Вирусы - дериваты (производные) клеточных генетических структур, ставших относительно автономными, но сохранившими зависимость от клеток.
Сочетание ПЦР и культивирования. Ценность методов культивирования в стоматологии
Федеральное государственное бюджетное учреждение "Центральный научно-исследовательский институт стоматологии и челюстно-лицевой хирургии" Минздравсоцразвития Российской Федерации, Москва
Московский государственный медико-стоматологический университет им. А.И. Евдокимова Минздрава РФ
Центральный научно-исследовательский институт стоматологии и челюстно-лицевой хирургии Минзрава России
ФГБУ «ЦНИИС и ЧЛХ» Минздрава России, Москва
Журнал: Стоматология. 2014;93(5): 28‑31
С помощью метода полимеразной цепной реакции (ПЦР) и масс-спектрометрии изучены особенности микрофлоры пародонтальных карманов при агрессивном и хроническом течении пародонтита. Обследованы 17 пациентов в возрасте от 25 до 70 лет без тяжелой соматической патологии. Пилотное исследование показало высокую распространенность облигатных пародонтопатогенов в пародонтальных карманах при проведении ПЦР-диагностики; в тоже время при использовании методики масс-спектрометрии удалось получить сведения о наличии других патогенов, на которые не были заложены праймеры в диагностический набор ПЦР.
Эффективное лечение пациентов с инфекционно-воспалительными заболеваниями пародонта, как правило, предполагает в комплексе целого ряда вмешательств использовать медикаментозное воздействие на пародонтопатогенные бактерии как основной этиологический фактор пародонтита 1.
Несмотря на доказанную клиническую эффективность антисептиков и антибиотиков, они имеют ряд недостатков, которые могут состоять как в недостаточно эффективном их действии вследствие как исходной, так и возникающей в процессе лечения резистентности микрофлоры, так и в выраженных побочных эффектах, характерных для антибиотикотерапии [2, 4, 11]. Поэтому представляется целесообразным изучить наиболее перспективные методы микробиологического исследования, в частности, полимеразную цепную реакцию (ПЦР) и масс-спектрометрию, для получения наиболее объективной информации о видовом составе микрофлоры с последующим выбором адекватных антимикробных средств местного воздействия.
Для проведения микробиологической диагностики современные лаборатории предлагают использовать ПЦР с применением стандартных маркеров известных патогенов. При этом масс-спектрометрия, позволяющая путем высокоточного «взвешивания» молекул определить видовую принадлежность микроорганизма и безусловно являющаяся очень перспективным методом, применяется чрезвычайно редко [2, 9, 10].
Каждая из предложенных методик имеет как недостатки, так и преимущества. Так, при проведении ПЦР-диагностики удается обнаружить ДНК микроорганизмов, которые не всегда удается культивировать по многим причинам (недостаточная анаэробизация, пропитывание штифта, попадание кислорода, взбалтывание при транспортировке). Но при всей ценности данная методика дает лишь ответ на вопрос о присутствии конкретного вида патогена с учетом заложенных в диагностический набор праймеров, поскольку преимущественно применяется метод качественной оценки. И в таком случае микроорганизмы необязательно должны присутствовать в живом виде.
Высокоточная методика масс-спектрометрии позволяет установить видовую принадлежность всех жизнеспособных и культивируемых бактериальных форм [2, 9, 10, 12]. Именно сохранение жизнеспособности и свойств культивирования остается наиболее сложной проблемой при заборе и транспортировке образцов бактериальных культур, и в этом на сегодня - основная сложность методики. Но с ее помощью можно определить наличие патогенов, на которые не закладываются праймеры в ПЦР.
Вследствие сказанного понятна необходимость сравнительной оценки степени информативности каждого из указанных методов, чтобы объективно определить либо наиболее показательный из них, либо их сочетание в целях получения максимальной информации, важной для клинициста.
Материал и методы
Обследованы 14 пациентов в возрасте от 25 до 70 лет с воспалительными поражениями пародонта разных степеней тяжести. Забор материала был проведен в области 18 зубов: 6 фронтальных и 12 жевательных. Обследование предполагало сбор анамнеза и осмотр пациентов. Дополнительные методы включали в себя ортопантомографию и микробиологическое исследование.
Жалобы пациентов были типичными для пародонтита разных степеней. При осмотре фиксировали кровоточивость и отечность десны, подвижность зубов I-III степени, глубину пародонтальных карманов (ПК) от 3 до 7 мм, наличие гноетечения в области отдельных ПК.
Рентгенологически определялись в основном смешанный (неравномерный) тип деструкции костной ткани, нарушение целостности или отсутствие кортикальной пластинки разной степени, очаги остеопороза.
Забор материала. Для изучения микробного содержимого ПК стерильный бумажный штифт стерильным пинцетом помещали в ПК, где он в течение 7-10 с пропитывается его содержимым (рис. 1, см. на цв. вклейке) Рис. 1. Забор микробиологического материала из ПК стерильным бумажным штифтом. , после чего его помещали в пробирку с жидкой питательной средой Brain Heart Infusion Broth (рис. 2, см. на цв. вклейке). Рис. 2. Помещение материала в питательную среду Brain-Heart Infusion Broth.

Пробирку плотно закрывали, проводили маркировку образца и не более чем в течение 2 мин помещали в анаэростат с предварительно увлажненным газ-пакетом. Анаэростат перевозили в лабораторию научно-производственного центра «МикроМир» (рис. 3, см. на цв. вклейке). Рис. 3. Анаэробизация в компактном переносном анаэростате АЭ-01; образцы микробиологического материала готовы к транспортировке в лабораторию.
В лаборатории проводили параллельный рассев образцов на питательную среду Brain Heart Infusion с добавлением 10% стерильной дефибринированной крови с последующей идентификацией микроорганизмов (рис. 4, см. на цв. вклейке). Рис. 4. Чашка Петри с полученными бактериальными культурами.
ПЦР - это получение множества копий специфического фрагмента ДНК в пробирке (in vitro). Она основана на трехэтапном циклическом процессе, в результате которого многократно увеличивается количество специфического фрагмента ДНК: денатурация, гибридизация праймеров, полимеризация, или элонгация, цепи ДНК.
ПЦР-тестирование клинического материала проводили в реальном времени с использованием набора праймеров фирмы «Литех» к 6 пародонтопатогенам: Prevotella intermedia, Treponema denticola, Aggregatibacter actinomycetemcomitans (Actinobacillus actinomycetemcomitans), Porphyromonas gingivalis, Porphyromonas endodontalis, Fusobacterium nucleatum [1] .
Масс-спектрометрия - высокоточная методика, позволяющая установить видовую принадлежность всех жизнеспособных и культивируемых бактериальных форм. Это - физический метод измерения отношения массы заряженных частиц вещества к их заряду. Масс-спектрометр представляет собой прибор, способный в условиях вакуума разделять находящиеся в газовой фазе заряженные частицы вещества согласно отношению их массы к заряду (m/z ratio).
Метод масс-спектрометрии применяли, чтобы получить более широкое представление о характере микробного содержимого ПК после получения клонированных колоний бактериальных культур в соответствии со сроками и условиями культивирования.
Результаты и обсуждение
Пилотное исследование выявило высокую распространенность облигатных пародонтопатогенов в ПК при агрессивном и хроническом течении пародонтита всех степеней тяжести.
Анализ результатов ПЦР-диагностики показал наличие A.a. у 64% обследованных пациентов с пародонтитом. Важно отметить, что во всех случаях агрессивного пародонтита было зафиксировано присутствие данного микроорганизма.
P.g. обнаружены у 50% пациентов с пародонтитом, P.i. - у 36%, P.e. - у 14%, F.n. - у 7%. Следует отметить, что пародонтопатоген T. denticola не выявлен ни в одном из образцов при ПЦР-тестировании.
При сравнении данных установлено, что A.a. чаще всего встречается при хроническом генерализованном пародонтите (ХГП) легкой и средней степени тяжести и при быстропрогрессирующем пародонтите. При тяжелой степени ХГП в образцах чаще всего встречаются P.g. и F.n.
Анализ результатов масс-спектрометрии показал, что только ее использование не всегда позволяет выявить облигатные пародонтопатогены, поскольку данная методика учитывает наличие только жизнеспособных и культивируемых бактериальных форм, получение которых не всегда возможно по ряду причин: недостаточная анаэробизация, недостаточное пропитывание штифта, попадание кислорода, взбалтывание при транспортировке и др.
В то же время удалось получить сведения о наличии нехарактерных для полости рта патогенов как с аэробным, так и с анаэробным типом дыхания, присутствие которых обычно выявляется при воспалительных заболеваниях кожи (Staph. aureus spp., Strept. pyogenes spp., St. epidermidis), желудочно-кишечного тракта (Wolinella recta, Staph. aureus, Esherichia coli, Enter. faecalis), мочеполовой системы (Enter. faecium, Staph. epidermidis), ЛОР-органов (Staph. aureus spp., Strept. pyogenes spp., Strept. pyogenes spp., Staph. aureus spp., Staph. epidermidis spp., Klebsiella spp.) в соответствующем материале (экссудате, слизи, кале, моче и т.д.).

Результаты исследования приведены в таблице.
Метод ПЦР, безусловно, очень значим для стоматологов, и на сегодняшний день он общепризнан в мире в качестве основного диагностического метода в пародонтологии. Тем не менее и он не лишен целого ряда недостатков. Так, ориентироваться на 4-8 видов микроорганизмов в целях оценки тяжести процесса, его формы, а также лечебного эффекта представляется не вполне резонным. Трудно представить себе, что эти (пусть и безусловно весьма важные) патогены «работают» сами по себе - без симбиоза с остальными 400-700 видами бактерий. Поэтому констатация тяжести процесса и оценка эффекта лечения представляются весьма условными.
Особенности микрофлоры при разных патологических процессах в тканях пародонта были выявлены параллельным проведением ПЦР-диагностики и масс-спектрометрии.
Сочетание 2 методов идентификации позволило провести углубленный анализ микробного пейзажа ПК, в частности, установить патогены, не рассматриваемые ранее в качестве специфичных для пародонтита и участвующие в воспалительных процессах других органов и систем: Staph. epidermidis, Micrococcus luteus, Esherichia coli, Klebsiella pneumoniae и др. Это расширяет наши представления о микробной этиологии воспалительных заболеваний пародонта и может послужить целям совершенствования лечебной антимикробной тактики.
[1] Aggregatibacter actinomycetemcomitans — A.a.; Porphyromonas gingivalis — P.g.; Prevotella intermedia — P.i.; Porphyromonas endodontalis — P.e.; Fusobacterium nucleatum — F.n.; Staphylococcus — Staph.; Streptococcus — Strept.; Micrococcus — Micr.; Enterococcus — Enter.; Stenotrophomonas — Stenotr.; Veillonella — Veill.
Московский государственный медико-стоматологический университет
Кафедра факультетской хирургической стоматологии и имплантологии;
кафедра микробиологии, вирусологии, иммунологии Московского государственного медико-стоматологического университета
ГБОУ ВПО «Московский государственный медико-стоматологический университет им. А.И. Евдокимова» Минздрава России, Россия
ГБОУ ВПО «Московский государственный медико-стоматологический университет им. А.И. Евдокимова» Минздрава России, Российская Федерация;Дагестанская государственная медицинская академия, Махачкала, Российская Федерация
Кафедра микробиологии, вирусологии, иммунологии стоматологического факультета Научно-исследовательского медико-стоматологического института
Применение пероральных цефалоспоринов при амбулаторных хирургических операциях в челюстно-лицевой области на основании ПЦР-диагностики
Журнал: Стоматология. 2014;93(5): 43‑47
Царев В.Н., Чувилкин В.И., Ахмедов Г.Д., Чувилкина Е.И., Гаджиев Ф.Н., Никитин И.В. Применение пероральных цефалоспоринов при амбулаторных хирургических операциях в челюстно-лицевой области на основании ПЦР-диагностики. Стоматология. 2014;93(5):43‑47.
Tsarev VN, Chuvilkin VI, Akhmedov GD, Chuvilkina EI, Gadzhiev FN, Nikitin IV. PCR rationale for use of oral cephalosporins by oral surgery procedures. Stomatologiya. 2014;93(5):43‑47. (In Russ.).
Представлены опыт детекции ДНК вирулентных видов бактерий - возбудителей одонтогенного воспаления - с помощью полимеразной цепной реакции (ПЦР), обоснование и оценка эффективности применения пероральных цефалоспоринов в послеоперационном периоде при амбулаторных хирургических операциях. Исследован гнойный экссудат у 48 пациентов в возрасте от 18 до 68 лет, перенесших амбулаторно операции по поводу цистогранулем, перикоронита. Установлено, что компоненты ассоциации возбудителей, выявленные с помощью ПЦР-диагностики, соответствуют по спектру чувствительности цефалоспоринам III поколения. Схема лечения включала в себя применение цефтибутена по 400 мг/сут однократно перорально. Показана эффективность применении цефтибутена по данным клинико-лабораторного и иммунологического исследования в послеоперационном периоде.
Проблема совершенствования методов профилактики, диагностики и лечения инфекционных воспалительных заболеваний челюстно-лицевой области (ЧЛО) по-прежнему актуальна, так как высок процент таких больных, возрастает частота развития атипично и хронически протекающих форм воспаления на фоне измененной реактивности организма и изменяющихся свойств микроорганизмов, постоянно приспосабливающихся к новым условиям существования и приобретающих разнообразные механизмы устойчивости к антибактериальным препаратам [9, 10].
Наиболее часто (19-23% случаев) встречающийся анаэробный компонент микробной ассоциации при одонтогенных воспалительных процессах ЧЛО, по данным разных авторов, это представители группы бактероидов (род Bacteroides), а также пигментообразующие микроорганизмы, относящиеся к родам Porphyromonas, Prevotella. Реже встречаются Fusobacterium spp., Peptostreptococcus anaerobius, Peptococcus niger (12-16%), а также Veillonella spp. и представители «актиномицетной» линии - они определяются примерно в 4-8% случаев [1, 4, 8]. Однако известны обнаруживаемые в полости рта вирулентные виды бактерий, которые невозможно идентифицировать традиционным бактериологическим методом, даже с применением техники анаэробного культивирования [2, 3].
Выявление таких видов, как Treponema denticola, Eikenella corrodens, Capnocytophaga spp., затруднено в связи с трудностями их культивирования на питательных средах. Есть определенные сложности и при выделении основных пародонтопатогенных видов 1-го порядка - Porphyromonas gingivalis и Tannerella forsythia [1, 3]. Кроме того, при использовании анаэробного метода культивирования диагностика нередко бывает малоэффективной, поскольку занимает много времени - 5-7 сут и более. Особенности транспортировки материала, необходимость использования большого количества питательных сред, газовых смесей для культивирования, идентификационных систем - все это недостатки традиционного метода диагностики [4, 7, 8].
Отсутствие возможности проведения современной и своевременной диагностики при данной патологии создает трудности в выборе адекватной антибактериальной терапии и предпосылки к развитию грозных осложнений.
Среди антибактериальных средств, которые по механизму и спектру действия соответствуют потенциальным возбудителям одонтогенной инфекции, привлекает внимание группа β-лактамных антибиотиков - цефалоспоринов [6, 10].
Цефалоспорины - высокоэффективные бактерицидные агенты с относительно низкой цитотоксичностью. Цефалоспорины I поколения наиболее активны в отношении грамположительных организмов, высокочувствительны к β-лактамазам грамнегативных продуцентов, имеют короткий период полувыведения из сыворотки и дешевле других цефалоспоринов [5, 6]. Большинство цефалоспоринов II и III поколений (за исключением цефокситина) активны против Haemophilus influenzae. Все цефалоспорины названных подгрупп (за исключением цефсулодина) активны в отношении Klebsiella, Escherichia coli, Proteus mirabilis, но только препараты III поколения проявляют активность против всех бактерий семейства Enterobacteriaceae и анаэробных грамотрицательных бактерий рода Bacteroides, а препараты III и IV поколений - еще и против Pseudomonas aeruginosa и других неферментирующих бактерий 6. Благодаря удлиненному периоду полувыведения, их можно назначать для приема только 1 или 2 раза в день, хотя они дороже своих предшественников. Хорошие перспективы создает комбинация этих антибиотиков с клавулановой кислотой, которая эффективно ингибирует активность β-лактамаз в отношении цефалоспоринов [5].
Наконец, у цефалоспоринов IV поколения (цефапим) все указанные позитивные качества выражены в максимальной степени, но в отличие от других групп препаратов цефалоспорины IV поколения предназначены исключительно для парентерального применения. Их особенностью является химическая структура цвиттериона - одновременное наличие в молекуле 2 зарядов: положительного (четвертичный азот циклопентапиридиновой группы) и отрицательного (цефемовое ядро). Благодаря этому препарат быстрее проникает через наружную мембрану грамотрицательных бактерий и эффективно связывается с мишенью - пенициллинсвязывающими белками [5, 8].
Цель исследования - оценить эффективность молекулярно-биологического метода диагностики при одонтогенных воспалительных процессах ЧЛО и эффективность послеоперационного лечения пациентов с применением цефалоспорина III поколения для перорального приема - цефтибутена.
Проведено обследование 48 пациентов (20 мужчин и 28 женщин) в возрасте от 18 до 58 лет. Пациенты получали амбулаторную хирургическую помощь по поводу цистогранулем (n=22) и перекоронита дистопированного или ретинированного 3 моляра (n=26) в КДЦ МГМСУ им. А.И. Евдокимова.
Под внутривенным наркозом и (или) местной анестезией 10-20 мл 0,5% Sol.Lidocaini производили разрез слизистой оболочки (внутриротовым доступом с учетом локализации процесса). Операцию цистэктомии или удаления 3 моляра выполняли традиционными методами. После операции накладывали асептическую повязку.
Отбор проб для молекулярно-биологического исследования (гнойный экссудат) в соответствии с протоколом фирмы-производителя тест-систем производили бумажными чипами, которые помещали в пробирки Эппендорфф с подготовленным стерильным физиологическим раствором. Материал для исследования доставляли в лабораторию кафедры микробиологии, вирусологии и иммунологии МГМСУ в течение 2 ч.
ДНК маркерных видов выделяли методом ускоренной пробоподготовки с помощью реактива Реалекс. Для осуществления полимеразной цепной реакции (ПЦР) использовали амплификатор отечественного производства Терцик МС-2, в который помещали пробирки с реакционной смесью, термошейкеры, ультрацентрифуги и другое стандартное оборудование. Клонированные образцы ДНК анализировали с помощью электрофореза в 1,6% агарозном геле после окрашивания бромистым этидием. Просмотр и фотографирование гелей проводили, используя трансиллюминатор ТСР-25 М («Vilber Lourmat», Франция) при длине волны УФ 12-24 ч. [1, 3].
Диагностику 5 маркерных видов пародонтопатогенов - Aggregatibacter actinomycetemcomitans (Aa), Porphyromonas gingivalis (Pg), Prevotella intermedia (Pi), Tannerella forsythia (Tf), Treponema denticola (Td) - осуществляли, используя отечественный набор для ПЦР МультиДент-5 («ГенЛаб», Россия). По существующей рабочей классификации первые 3 вида относятся к пародонтопатогенам 1-го порядка, прочие - 2-го порядка [3]. Маркеры других 6 видов пародонтопатогенов 2-го порядка - Peptostreptococcus micros (Pm), Fusobacterium nucleatum/periodonticum (Fn), Campylobacter rectus (Cr), Eubacterium nodatum (En), Eikenella corrodents (Es). Capnocytophaga spp. (S. gingivalis, C. ochraces, C. sputigena (C sp) - выявляли с использованием тест-системы micro-IDent plus («Hain Lifescience», Германия).
Обе использованные нами диагностические системы содержали комбинации специфических праймеров нескольких видов, т.е. использовалась мультиплексная (мультипраймерная) ПЦР в соответствии с медицинской технологией, утвержденной Росздравнадзором для применения в практическом здравоохранении (ФС-2006/043-У; срок действия - до 2016 г.)
Одновременно выполняли иммунологическое исследование и исследование венозной крови с моноклональными CD-антителами для фенотипирования клеток методом прочной цитометрии, определение фагоцитарной активности и бактериологическое исследование с применением техники анаэробного культивирования в анаэростатах с бескислордной газовой смесью («Himedia», Индия). Для получения демонстраций готовили мазки из выделенных чистых культур и осуществляли микрофотографирование с использованием цифровой техники микроскопа Eclips («Nikon», Япония).
При статистической обработке результатов пользовались методами непараметрической статистики с применением критерия Манна-Уитни.

При проведении молекулярно-биологических исследований нами была проанализирована частота обнаружения представителей бактериальных видов пародонтопатогенной группы 1-го и 2-го порядка в раневом экссудате, полученном у пациентов при амбулаторном хирургическом лечении (цистэктомия, удаление 3 моляра) - табл. 1.
В результате исследования получили следующее процентное соотношение по 11 бактериальным видам. Как отмечено в табл. 1, такой приоритетный патоген, как Aa, выделяли из полученного гнойного экссудата в 25,0% случаев. Вид Pg также относится к приоритетным пародонтопатогенным видам и обнаруживался у 50,0% пациентов. 3-й пародонтопатогенный вид 1-го порядка - Tf - выделен в 66,7% случаев. Интересно, что сочетание 2-3 перечисленных видов 1-го порядка наблюдали у 36 (75%) пациентов.
Среди пародонтопатогенов 2-го порядка доминировали представители 2 видов - Pi (идентифицированы нами в 62,5% случаев) и Fn - в 50% случаев. В 3 раза реже определяли генетические маркеры Td и Pm - соответственно в 22,9 и 20,8% случаев. Прочие представители пародонтопатогенов 2-го порядка присутствовали в виде единичных находок (в 4,2-8,3% случаев). Однако сочетание 2-4 видов 1-го и 2-го порядка наблюдалось у подавляющего большинства пациентов - у 45 (93,8%) человек.

Полученные данные были подтверждены для культивируемых возбудителей при бактериологическом методе исследования. Результаты исследования чувствительности выделенных штаммов анаэробных бактерий с помощью кассетного микрометода к антибиотикам группы цефалоспоринов для перорального приема представлены в табл. 2.
Очевидно, что минимальная подавляющая концентрация (МПК) цефтибутена по сравнению с аналогами для перорального применения (цефалексин, цефадроксил, цефаклор) была достоверно ниже в отношении всех исследуемых штаммов и составляла в наших исследованиях от 0,06 до 4,0 мкг/мл. Последнее объясняется расширенным в сравнении с таковым у аналогов 1-й и 2-й группы для перорального приема спектром препарата, который относится к группе цефалоспоринов III поколения. Помимо анаэробных пародонтопатогенных бактерий, к нему проявляли высокую чувствительность микроаэрофильные бактерии - Aa, Steptococcus sanguis и Streptococcus intermedius (табл. 2).

Полученные данные явились основанием для назначения цефтибутена в качестве препарата для антибактериальной химиотерапии по 400 мг/сут перорально на 5 дней послеоперационного периода. После лечения наблюдали благоприятную динамику всех клинических параметров (выраженность болевого синдрома, экссудация, репарация, сроки снятия швов). К числу основных лабораторных критериев эффективности лечения относились иммунологические препараты крови пациентов (табл. 3).
У пациентов с одонтогенными воспалительными процессами в послеоперационном периоде на фоне лечения цефтибутеном наблюдалось повышение основных иммунологических показателей на 3-5-е сутки, которое было исходно сниженным (СД3 + , СД4 + Фагоцитарный индекс - ФИ). Напротив, повышенные при 1-м обращении уровни IgA и IgG снижались. На 5-е сутки после операции большинство иммунологических показателей нормализовались, включая уровень IgM, который был исходно высоким. Однако, в этот период сохранялась высокая фагоцитарная активность и фагоцитарное число (ФЧ) фагоцитарного процесса (p<0,01), что можно расценивать как благоприятный признак с точки зрения очищения и заживления раны.
На рис. 1 и 2 (см. на цв. вклейке) Рис. 1. Мазок из чистой культуры возбудителя пародонтопатогенной группы 1 порядка - Porphyromonas gingivalis. Окраска по Граму. Объектив ×90, масляная иммерсия. Рис. 2. Мазок из чистой культуры возбудителя пародонтопатогенной группы 2 порядка - Actinomyces israelii. Окраска по Граму. Объектив ×90, масляная иммерсия. представлены фотографии препаратов чистых культур возбудителей Pg и Actinomyces israelii, полученные с помощью цифровой камеры микроскопа Eclips («Nikon», Япония).
Эффект, достигнутый при использовании цефтибутена, по имеющимся данным, может быть объяснен иммуномодулирующими свойствами препарата и его влиянием на экспрессию кортизолсвязывающих молекул, что обеспечивает увеличение соотношения кортизолсвязывающих рецепторов 2-го и 1-го типа и, таким образом, нормальную адаптацию к операционному стрессу [4, 5].
Использование молекулярно-генетического метода диагностики позволяет в течение 12-24 ч с момента оказания ургентной помощи определить видовой состав микрофлоры. Высокая чувствительность метода, быстрота получения результатов обусловливают высокую эффективность данной методики при диагностике воспалительных процессов в области головы и шеи. Возможность оперативно получить результаты такого исследования дает врачу возможность быстро и точно подобрать антибактериальную терапию, если известен спектр чувствительности возбудителя. При необходимости его можно уточнить стандартным диско-диффузионным методом [6, 7, 10].
Одним из вариантов эффективной антибактериальной терапии является применение современных антибиотиков - цефалоспоринов III поколения, что обосновано в настоящем исследовании данными об этиологии одонтогенных воспалительных процессов и возможности перорального приема лекарственной формы. Помимо этого, цефалоспорины III поколения, в частности - препарат цефтибутен, обладают расширенным спектром действия, который включает в себя отрицательные факультативно и облигатно-анаэробные бактерии, в том числе пародонтопатогенные штаммы, устойчивые к β-лактамазам [9, 10].
Сочетание новых подходов к диагностике и лечению одонтогенных воспалительных процессов позволяет повысить эффективность амбулаторной хирургической медицинской помощи пациентам. Большие возможности в диагностике одонтогенных инфекций открывает молекулярно-генетический метод исследования. ПЦР, лежащая в основе данного метода, позволяет многократно умножить за несколько часов специфический фрагмент молекулы ДНК возбудителя и обнаружить его в исследуемом материале даже при незначительном количестве последнего. При этом нет необходимости соблюдать особые условия стерильности взятия материала, практически нет ограничений, касающихся времени и способа доставки материала в лабораторию.
Итак, вышеизложенное позволяет заключить, что:
- в этиологии воспалительных процессов одонтогенной природы, при которых требуется амбулаторное хирургическое вмешательство, существенную роль играют приоритетные возбудители пародонтопатогенной группы 1-го порядка и ассоциации пародонтопатогенов 1-го и 2-го порядка, которые выявляются методом мультиплексной ПЦР, соответственно у 75 и 93% пациентов;
- наибольшая чувствительность пародонтопатогенов к антибиотикам группы цефалоспоринов для перорального приема выявлена у препарата III поколения цефтибутена, что позволяет рекомендовать его для лечения пациентов в послеоперационном периоде короткими курсами (по 400 мг/сут в течение 5 сут);
- клиническое применение цефтибутена в послеоперационном периоде характеризуется благоприятной динамикой клинических симптомов и параметров иммунного статуса, что согласуется с известными данными о наличии иммуномодулирующей активности у цефалоспоринов III поколения.
Современная молекулярная диагностика в стоматологии
Некоторые заболевания полости рта лечатся назначением антибактериальных препаратов. Но бактериальная флора в полости рта может быть устойчивой к некоторым группам антибактериальных препаратов. Современные методы молекулярной диагностики в стоматологии открывают новые возможности в изучении этиологии и патогенеза заболеваний полости рта. Ведь идентификация малоизученных бактериальных организмов, которые способствуют развитию патологических процессов в тканях челюстно - лицевой области, будет оказывать большую пользу в лечении болезней полости рта.
Универсальные праймеры - разновидность молекулярной диагностики
На сегодня в качестве молекулярной диагностики используют универсальные праймеры, характеризующие весь микробный биоценоз. Для этого применяют метод культивирования. Из-за объективных ограничений метода ПЦР и иммунохимического анализа нужно проверить праймеры и антитела на чистой культуре бактерий. После такой проверки возможно применение новых препаратов в молекулярной диагностике пародонтита и других патологий полости рта.
При лечении воспалительных заболеваний пародонта часто применяются антибиотики.
Однако существует проблема, которая состоит в выборе группы антибактериальных средств, контроле их эффективности и выявлении резистентности бактерий к назначенной группе антибактериальных препаратов. Такие проблемы могут быть решены с помощью молекулярной диагностики.
Так как назначение антибактериальных препаратов нередко производится без учета вышеперечисленных факторов, внедрение молекулярной диагностики, в частности ПЦР, является довольно актуальным вопросом в клинической стоматологии.
Методы молекулярной диагностики в стоматологии:
- универсальные праймеры;
- ПЦР;
- детекция продуктов амплификации.
Роль молекулярной диагностики в изучении генов
Использование методов молекулярной диагностики способствует развитию исследований в сфере изучения генов, которые устойчивы к антибиотикам. Например, ПЦР была использована с целью определения локусов ДНК, которые устойчивы к эритромицину и тетрациклину у анаэробов. Местное назначение тетрациклина может способствовать появлению ПК бактерий, которые устойчивы к этому препарату. По данным некоторых исследований, приблизительно 12% бактерий ротовой полости являются устойчивыми к препаратам тетрациклинового ряда.
Не менее интересные результаты продемонстрировали исследования образцов зубных бляшек и слюны, полученные от 20 здоровых взрослых, которые не принимали антибиотики на протяжении 3 месяцев. Было выявлено 8 классов генов устойчивости к тетрациклину, которые кодируют рибосомный белок. Гены устойчивости грамотрицательных бактерий локализируются по всему геному и связаны с большими перемещающимися плазмидами. Гены устойчивости бактерий размещены на малых передающихся плазмидах.
Молекулярная диагностика выявляет расположение генов устойчивости к антибиотикам
Доказано, что некоторые бактерии распространяют гены устойчивости к тетрациклину с помощью транспозонов.
Было установлено, что многие виды бактероидов имеют большое количество хромосомных элементов с геном устойчивости к тетрациклину. Данные элементы встроены в хромосому бактериоидов и самостоятельно передаются от хромосомы донора к хромосоме реципиента.
Таким образом, изучение устойчивости микробной флоры ротовой полости к антибактериальным препаратам является актуальным и приоритетным направлением в стоматологии. Большое значение в этом направлении имеет молекулярная диагностика.
Исследование условно-патогенных микроорганизмов методом ПЦР в реальном времени у больных пародонтитом
Полость рта человека населяют разные по видовому составу сообщества микроорганизмов. В их число входят как нормальная флора, так и условно-патогенные микроорганизмы, которые могут являться этиологическими агентами пародонтита. Количественное и качественное выявление ДНК основных пародонтопатогенов позволяет оценить степень дисбиотических нарушений микрофлоры ротовой полости, назначить адекватную терапию и оценить эффективность лечения.
Важная роль микробного фактора в этиологии и патогенезе воспалительных заболеваний пародонта определяет актуальность исследований в этом направлении.
Полость рта можно отнести к одному из идеальных для обитания микроорганизмов биотопов организма человека. Этот биотоп подразделяется на ряд суббиотопов с учетом анатомического строения и других особенностей отделов полости рта: десневую бороздку, язык, пародонтальный карман. Видовой состав микрофлоры этих суббиотопов напрямую зависит как от местных факторов защиты, так и от общих. К местным факторам можно отнести слюну и механизмы резистентности самой слизистой оболочки: фагоцитоз, выработка макрофагами и другими клетками биологически активных веществ, цитокинов.
Нормальная микрофлора ротовой полости играет не последнюю роль в защите организма человека от заболеваний. Практически у любого человека в полости рта, кроме ее естественных обитателей (нормофлоры, представленной лакто- и бифидобактериями), выявляются условно-патогенные и патогенные микроорганизмы.
Нарушение количественных соотношений между нормальной и условно-патогенной флорой приводит к развитию дисбиотических состояний и характеризуется снижением количества лакто- и бифидобактерий и ростом условно-патогенных микроорганизмов.
При пародонтите всегда имеют место дисбиотические нарушения. Доказано, что развитие пародонтита наиболее часто ассоциируется с увеличением количества и персистенцией в тканях пародонта Prevotella intermedia, Tannerella forsythensis, Treponema denticola, Actinobacillus actinomycetemcomitans, Porphyromonas gingivalis.
Основная трудность выявления указанных патогенов связана с проблемой культивирования анаэробных микроорганизмов и количественной оценкой результатов. Современные бактериологические лаборатории не всегда располагают необходимым оборудованием и питательными средами для культивирования облигатно-анаэробных микроорганизмов. В настоящее время в научных и практических исследованиях в области диагностики инфекционных заболеваний широкое распространение получил метод полимеразной цепной реакции (ПЦР). Использование ПЦР в реальном времени позволяет точно анализировать состав микрофлоры в десневой жидкости, зубной бляшке, слюне, выявляя ДНК искомых микроорганизмов в сложной смеси нуклеиновых кислот, а определение количества микроорганизмов обеспечивает возможность динамического наблюдения, что помогает адекватному выбору этиотропной терапии и оценке ее эффективности.
Целью настоящего исследования явилось выявление патогенных микроорганизмов в разных суббиотопах полости рта у больных пародонтитом и здоровых лиц методом ПЦР в реальном времени.
Материал и методы
ПЦР-диагностика десневой жидкости, зубных отложений, слюны проведена у 34 больных пародонтитом (20 женщин и 14 мужчин в возрасте от 27 до 65 лет) и 39 здоровых лиц (20 женщин и 19 мужчин в возрасте от 27 до 65 лет). Последние считали себя практически здоровыми, не имеющими сопутствующей патологии, полость рта у них была санирована, в тканях пародонта отсутствовали воспалительные изменения.
В группу больных пародонтитом вошли пациенты, не имевшие тяжелой фоновой патологии внутренних органов и систем, которая могла бы оказать заметное влияние на течение патологического процесса в пародонте. 62% из них обратились за помощью впервые, а 38% ранее лечились, за помощью обращались 1 раз в год. В зависимости от степени тяжести хронического генерализованного пародонтита их подразделили на 3 группы: с легкой степенью заболевания — 8 (23,5%) человек; со средней — 12 (35,3%); с тяжелым течением заболевания — 14 (41,2%).
Десневую жидкость для исследования отбирали с помощью стерильных бумажных полосок размером 0,3—0,8 мм,
одновременно в пробирку собирали слюну и стерильным ершиком снимали зубной налет.
ДНК для выявления микроорганизмов выделяли по методике «Проба-ГС» (ООО «НПО ДНК-Технология», Россия) согласно прилагаемой инструкции. Метод основан на сорбции ДНК на органическом носителе, отмывке примесей с последующей элюцией нуклеиновых кислот с сорбента. ПЦР и определение температуры плавления олигонуклеотидных проб проводили с помощью детектирующего амплификатора «ДТ-96» (ООО «НПО ДНК-Технология»). Для оценки результатов использовали программное обеспечение, прилагающееся к детектирующему амплификатору «ДТ-96».
Для постановки ПЦР в реальном времени использовали реагенты ООО «НПО ДНК-Технология» согласно инструкции производителя.
После амплификации по показателю индикаторного цикла (Ct) рассчитывали количество ДНК исследуемого инфекционного агента. Для исключения ложноотрицательных результатов учитывали показатель амплификации геномной ДНК человека (контроль взятия биологического материала).
Результаты и обсуждение
Полученные данные представлены в табл. 1—4.
Таблица 1. Данные о микроорганизмах у больных пародонтитом легкой степени в разных биотопах полости рта (n=8)

Таблица 2. Данные о микроорганизмах у больных пародонтитом средней тяжести в разных биотопах полости рта (n=16)

Таблица 3. Данные о микроорганизмах у больных пародонтитом тяжелой степени в разных биотопах полости рта (n=10)

Таблица 4. Показатели у лиц со здоровым пародонтом (n=39)

Как видно из табл. 4, у здоровых людей в исследуемых средах — слюне, десневой жидкости, зубной бляшке — изучаемые микроорганизмы обнаруживали в единичных случаях. У больных пародонтитом в десневой жидкости, зубных отложениях и слюне отмечали повышение количества Pr. intermedia, P. gingivalis, T. forsythensis, Tr. denticola. Микроорганизм A. actinomycetemcomitans выявляли в единичных случаях. Количество P. gingivalis зависело от степени тяжести заболевания, у больных с тяжелым течением заболевания этот показатель был больше.
У большинства пациентов со здоровым пародонтом исследуемых микроорганизмов в десневой жидкости не
выявлялось, в зубных отложениях и слюне обнаруживали T. forsythensis в незначительных количествах.
В группе здоровых лиц в отдельных случаях наибольшее количество микроорганизмов обнаруживалось в зубных отложениях, но и в них их количество не превышало 10 в 6,4 степени ГЭ/образец (для T. forsythensis); других микроорганизмов было еще меньше.
В группе пациентов с пародонтитом легкой степени у большинства обследованных в десневой жидкости выявляли 3 микроорганизма: P. gingivalis (медиана — 10 в 4,4 ГЭ/образец), T. forsythensis (10 в 5,4 степени) и T. denticola (10 в 4,8 степени). В зубных отложениях и слюне были отмечены все микроорганизмы, кроме A. actinomycetemcomitans.
В зубных отложениях пациентов с пародонтитом средней степени тяжести выявлялись все 5 микроорганизмов, тогда как в десневой жидкости и слюне не обнаруживалось A. actinomycetemcomitans.
Самым высоким количество патогенных микроорганизмов у больных пародонтитом было в десневой жидкости и зубных отложениях (до 10 в 8 — 10 в 9 ГЭ/образец), в слюне оно было на 1—2 порядка ниже.
Группы здоровых лиц и больных со средней и тяжелой степенями пародонтита статистически значимо различались по количеству выявленных микроорганизмов. Здоровые и больные с легкой и средней степенями тяжести заболевания различались по количеству всех видов микроорганизмов в десневой жидкости; в зубных отложениях статистически значимо различались количества Pr.intermedia (р=0,0001), P. gingivalis (р=2,8х10 в —7 степени), T. forsythensis (p=l,6х10 в —6 степени) и Tr. denticola (p=3х10 в —5 степени), в слюне — P. gingivalis (p=0,0003) и T. forsythensis (p=0,01). Группа больных с тяжелой степенью пародонтита по исследуемым показателям статистически значимо отличалась от группы здоровых лиц по количеству всех выявляемых микроорганизмов в десневой жидкости и зубных отложениях, а в слюне были найдены достоверные различия между группами только по количеству P. gingivalis (р=8х10 в —5 степени), T. forsythensis (р=0,003) и Tr. denticola (р=1,6х10 в —4 степени). Таким образом, в качестве материала для исследования по 5 основным пародонтопатогенам наиболее репрезентативными являются зубные отложения и десневая жидкость.
На рис. 1 и 2 представлено количество микроорганизмов через 1 мес после лечения: снятие зубных отложений, противовоспалительная терапия, хирургический кюретаж.
Рис. 1. Количество выявляемых микроорганизмов у больных пародонтитом через 1 мес после лечения (десневая жидкость).

Рис. 2. Количество выявляемых микроорганизмов у больных пародонтитом через 1 мес после лечения (зубные отложения).

Исследованием установлены различия в снижении уровня микроорганизмов. В десневой жидкости после лечения выявлялась Tr. denticola, а в зубных отложениях — Pr. intermedia и P. gingivalis.
Полученные нами данные доказывают участие микроорганизмов зубной бляшки и других суббиотопов полости рта в развитии воспалительных заболеваний пародонта. Данная патология развивается на фоне изменения количества и качественного состава микрофлоры полости рта, что приводит к появлению и размножению условно-патогенной микрофлоры, вызывающей воспаление в пародонте.
Группы здоровых и больных достоверно различались по количеству 5 основных пародонтопатогенных микроорганизмов. По-видимому, для развития воспалительных заболеваний пародонта принципиальным является не только количество каждого конкретного условно-патогенного микроорганизма, но и число видов, принимающих участие в развитии патологического процесса. В качестве материала для исследования предпочтительны зубные отложения и десневая жидкость.
ПЦР с детекцией результатов в режиме реального времени — достаточно точный метод изучения количественного и качественного состава пародонтопатогенной микрофлоры ротовой полости. Исследование 5 пародонтопатогенных микроорганизмов в различных суббиотопах ротовой полости целесообразно проводить при выборе терапии и для оценки эффективности проведенного лечения.
Читайте также:
